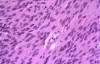

Vol. 37, n.º 3, 2004
REVISTA
ESPAÑOLA DE
Vol. 37, n.º 3, 2004 |
Javier Luis López-Hidalgo, Martín Olivar-Buera, Josefa Quesada-Hurtado1, Ana Barqueros-Ramírez1, Rafael Rodríguez-Zarauz1, Guillermo Lomeña-Álvarez2, Longinos Aceituno-Velasco1
Servicio de Anatomía Patológica. 1 Servicio de Ginecología y Obstetricia. 2 Servicio de Radiodiagnóstico. Hospital La Inmaculada. Avda. Dra. Ana Parra, s/n. 04600 Huércal-Overa. jalohi98@hotmail.com
RESUMEN
Objetivos: Se presenta un leiomiosarcoma primario de ovario. Estas neoplasias son extremadamente raras habiéndose comunicado aproximadamente unos 30 casos en la literatura revisada. Descripción del Caso: Una mujer de 84 años ingresó en el hospital por dolor e incremento del diámetro abdominal. La exploración demostró una gran masa sólida en región abdominal. Se realizó exéresis tumoral e histerectomía total más doble anexectomía con linfadenectomía ilíaca bilateral. El estudio anatomopatológico evidenció que se trataba de un leiomiosarcoma bien diferenciado de ovario derecho. Discusión: Los leiomiosarcomas primarios de ovario son neoplasias infrecuentes que deben incluirse en el diagnóstico diferencial de masas ováricas. En general son de comportamiento muy agresivo recomendándose un tratamiento quirúrgico radical. En este caso tras un seguimiento de 24 meses la paciente está libre de enfermedad.
Palabras clave: Ovario, leiomiosarcoma, tumores de músculo liso.
SUMMARY
Purpose: We report a case of ovarian leiomyosarcoma. Primary leiomyosarcoma of the ovary is extremely rare, and only 30 reported cases are known to the authors. Case description: An 84-year-old woman had noticed pain and abdominal mass. A physical examination revealed a solid tumor in the abdominal cavity. The excision of tumor with bilateral salpingo-oophorectomy, a histerectomy and pelvic lymphadenectomy was carried out. A diagnosis of pure well-differentiated leiomyosarcoma of the right ovary was made on pathological examination. Discussion: Primary ovarian leiomyosarcomas are rare and should be included in ovarian masses differential diagnosis. Usually behave very aggressively and aggressive surgical management is recommended. In this case the patient is free of disease at 24 months after diagnosis.
Key words: Ovary, leiomyosarcoma, smooth-muscle tumors.
INTRODUCCIÓN
Los leiomiosarcomas de ovario son neoplasias extremadamente raras que ocurren en mujeres postmenopáusicas causando dolor y distensión abdominal (1-4). Macro y microscópicamente son indistinguibles de los leiomiosarcomas uterinos (5,6). El diagnóstico diferencial se establece fundamentalmente con leiomiomas celulares de ovario, neoplasias malignas complejas ováricas con componente de músculo liso y sarcomas metastásicos de origen extraovárico (3,5,7).
El tratamiento recomendado es el quirúrgico sin que se haya establecido beneficio alguno con las terapias adyuvantes (3,8). Suelen ser de mal pronóstico y depende, entre otros factores, de las actividades mitótica y proliferativa, y de la expresión de p53 por las células neoplásicas (2,4).
DESCRIPCIÓN DEL CASO
Historia Clínica
Mujer de 84 años sin antecedentes de interés que ingresa por sensación de distensión abdominal y edemas en miembros inferiores de dos meses de evolución. A la exploración se encuentra caquéctica con regular estado general, bien hidratada y perfundida. Los genitales externos están atróficos, y presenta prolapso uterino total con cisto-rectocele de grado III. En el abdomen se aprecia masa abdominal que alcanza xifoides. Presenta edemas pretibiales bilaterales.
Los exámenes radiológicos (ECO y TAC abdominopélvicos) demuestran una gran masa de 233 x 146 mm de densidad heterogénea, cápsula gruesa con septos en su interior, localizada en región pélvica que desplaza asas intestinales.
Los hallazgos analíticos se encuentran dentro de la normalidad y los marcadores tumorales son negativos.
Con el diagnóstico de tumoración abdominal de probable origen ovárico se decide laparotomía exploradora.
Durante la laparotomía se observa una gran tumoración dependiente de ovario derecho que desplaza órganos. El útero está atrófico y el anejo izquierdo no muestra alteraciones relevantes.
Se envía la tumoración a Anatomía Patológica, y con el diagnóstico intraoperatorio de neoplasia maligna, se decide la histerectomía total con anexectomía izquierda y linfadenectomía ilíaca bilateral.
Descripción Macroscópica
Se identifica en anejo derecho una tumoración bien delimitada de coloración rojo-violácea de 30 x 24 cm. Externamente no se evidencian implantes tumorales. Al corte la tumoración se encuentra necrosada en el centro casi en su totalidad, preservándose únicamente áreas sólidas de coloración blanquecina y aspecto cerebroide en la periferia (fig. 1). Tras un tallado riguroso no se identifica ovario residual, observándose únicamente el oviducto rechazado por la neoplasia. El útero es atrófico con un cuello prominente, y el anejo izquierdo no muestra alteraciones macroscópicas relevantes.

Fig. 1. Imagen macroscópica de la sección de la tumoración ovárica.
Técnica Histológica
La pieza se fija de manera rutinaria en formol tamponado al 10%. Se toman muestras representativas para inclusión en parafina, que se cortan a 4 micras y se tiñen con hematoxilina y eosina. Las tinciones inmunohistoquímicas se realizan sobre secciones de parafina mediante la técnica de estreptavidina-biotina fosfatasa alcalina (kit de Master Diagnostica ultrasensitivo-Mlink) tras desenmascaramiento antigénico con tampón citrato en olla a presión. Se usan los siguientes anticuerpos monoclonales prediluidos (Master Diagnostica S.L.-Vitro S.A.): vimentina, actina de músculo liso, desmina, pancitoqueratina, CD34, factor VIII, proteína S-100, p53, Ki-67, y receptores de estrógeno y progesterona.
ESTUDIO MICROSCÓPICO
Microscópicamente el tumor se encuentra compuesto por una proliferación de células fusiformes de citoplasma rosado y núcleos en forma de cigarro puro con atipia (fig. 2) y un contaje mitótico de 10-12 mitosis/10 campos de gran aumento (CGA) (fig. 3). Existen focos de necrosis. No se observan signos de invasión capsular, vascular, ni perineural.

Fig. 2. Sección histológica del tumor ovárico. Células tumorales con atipia
franca (original, HE x400).
Fig. 3. Sección histológica del tumor ovárico. Las células tumorales son
fusiformes, de citoplasma rosado, núcleo ovalado y muestran actividad mitótica
(original, HE x400).
Desde el punto de vista inmunohistoquímico las células son positivas para vimentina y actina de músculo liso (fig. 4), y negativas para el resto de marcadores (desmina, pancitoqueratina, CD34, factor VIII, proteína S100, y receptores de estrógeno y progesterona). El índice proliferativo cuantificado mediante el Ki-67 es bajo (10%). La expresión de p53 es débil y focal en las células más atípicas.

Fig. 4. Las células neoplásicas expresan actina de músculo liso (original,
actina de músculo liso x400).
Tras la inclusión de más de 30 bloques del tumor no se identifican áreas de tumor mülleriano mixto maligno, adenosarcoma, teratoma inmaduro, tumor de células de Sertoli-Leydig heterólogo, ni de quiste dermoide.
El cérvix muestra alteraciones atribuibles a prolapso y el endometrio muestra atrofia glándulo-quística. El miometrio y el anejo izquierdo no muestran alteraciones microscópicas significativas. Los ganglios linfáticos iliacos están libres de metástasis.
El diagnóstico anatomopatológico fue leiomiosarcoma bien diferenciado de ovario derecho, estadio IA de la F.I.G.O. La paciente tras un seguimiento de 24 meses se encuentra asintomática, libre de enfermedad.
DISCUSIÓN
Los leiomiosarcomas de ovario son extremadamente raros, habiéndose comunicado aproximadamente unos 30 casos. Clínicamente se caracterizan por presentarse como masas anexiales de rápido crecimiento predominantemente en mujeres postmenopáusicas (1-4).
Anatomopatológicamente se caracterizan por ser tumores de tamaño variable, que son macro y microscópicamente indistinguibles de su contrapartida uterina (5,6). Están constituidos por una proliferación de haces entrelazados de células fusiformes que coexpresan en forma variable desmina, vimentina y actina de músculo liso (1,2). Muestran atipia franca y un número excesivo de figuras mitósicas, en un rango de 4 a 25 por 10 CGA, aunque como promedio se admite un número superior a 10 por 10 CGA (5).
El diagnóstico diferencial se establece en primer lugar con los leiomiomas celulares, y los criterios para distinguirlos están mal definidos debido a la infrecuencia de ambas neoplasias. Como sucede en el útero, se han comunicado ejemplos de leiomiomas mitóticamente activos de ovario. Se recomiendan usar los mismos criterios estrictos para el diagnóstico y clasificación de los tumores de músculo liso en ovario que en el útero. Aunque la actividad mitótica es un criterio útil e importante no es el único. A menos que la atipia nuclear esté también presente, como en este caso, el diagnóstico de leiomiosarcoma de ovario debe de hacerse con precaución (5,6).
En segundo lugar hay que distinguirlos de sobrecrecimientos de un componente de músculo liso en neoplasias complejas (tumor mülleriano mixto maligno, teratoma inmaduro, cistoadenoma mucinoso, adenosarcoma, tumor de células de Sertoli-Leydig heterólogo y quiste dermoide). Esto se consigue con un muestreo adecuado del tumor, en el que únicamente debe identificarse un componente leiomiosarcomatoso (3,5).
En tercer lugar deben diferenciarse de leiomiosarcomas parasitarios y metastásicos de útero, leiomiomatosis intravenosa y de la leiomiomatosis peritoneal diseminada que afecta secundariamente al ovario. Estos se descartan por el estudio histopatológico del útero y anejos (5).
En último lugar, debe descartarse una metástasis de origen extragenital (p. ej. tubo digestivo) mediante un TAC tóraco-abdominal completo, que en el caso presentado resultó negativo (7).
En cuanto al origen de los tumores de músculo liso de ovario, hay controversia. Probablemente se originan en las células musculares lisas de los vasos sanguíneos del hilio ovárico, de las fibras musculares lisas próximas al anclaje del ligamento ovárico, de células estromales ováricas multipotenciales, o de una metaplasia hacia músculo liso del estroma ovárico (5,9).
Los indicadores pronósticos histológicos incluyen la actividad mitótica, actividad proliferativa y expresión de p53 (2,4). En el presente caso todos los indicadores son de buen pronóstico pues las actividades mitótica y proliferativa son bajas, y la expresión de p53 es débil y focal. El pronóstico también depende, como en otros tumores ginecológicos, de diferentes factores (10,11): estadio F.I.G.O., localización (el leiomiosarcoma de ovario tiene peor pronóstico que su contrapartida uterina), grado histológico, metástasis en ganglios linfáticos, edad al diagnóstico, presencia de ascitis y la raza.
En general son de comportamiento muy agresivo por lo que se recomienda un tratamiento quirúrgico radical con histerectomía total abdominal, salpingooforectomía bilateral y extirpación de la/s masa/s tumoral/es. Debido a los pocos casos estudiados no se han establecido los beneficios de la quimioterapia y/o radioterapia (3,8).
En este caso, la paciente tras un seguimiento de 24 meses, está libre de enfermedad.
AGRADECIMIENTOS
Al Dr. Eladio Mendoza, del Departamento de Anatomía Patológica de los Hospitales Universitarios Virgen del Rocío, por su colaboración y opinión acerca del caso.
BIBLIOGRAFÍA
Friedman HD, Mazur MT. Primary ovarian leiomyosarcoma. An immunohistochemical and ultrastructural study. Arch Pathol Lab Med 1991; 115: 941-5.
Nogales FF, Ayala A, Ruiz-Avila I, Sirvent JJ. Myxoid leiomyosarcoma of the ovary: analysis of three cases. Hum Pathol 1991; 22: 1268-73.
Piura B, Rabinovich A, Yanai-Inbar I, Cohen Y, Glezerman M. Primary sarcoma of the ovary: report of five cases and review of the literature. Eur J Gynaecol Oncol 1998; 19: 257-61.
Nasu M, Inoue J, Matsui M, Minoura S, Matsubara O. Ovarian leiomyosarcoma: an autopsy case report. Pathol Int 2000; 50: 162-5.
Prayson RA, Hart WR. Primary smooth-muscle tumors of the ovary. A clinicopathologic study of four leiomyomas and two mitotically active leiomyomas. Arch Pathol Lab Med 1992; 116: 1068-71.
Scully RE, Young RH, Clement PB, eds. Tumors of the ovary, maldeveloped gonads, fallopian tube and broad ligament. 3rd ed. Washington DC: AFIP; 1998.
Young RH, Scully RE. Sarcomas metastatic to the ovary: a report of 21 cases. Int J Gynecol Pathol 1990; 9: 231-52.
Monk BJ, Nieberg R, Berek JS. Primary leiomyosarcoma of the ovary in a perimenarchal female. Gynecol Oncol 1993; 48: 389-93.
Vierhout ME, Pijpers L, Tham MN, Chadha-Ajwani S. Leiomyoma of the ovary. Acta Obstet Gynecol Scand 1990; 69: 445-7.
DiSaia PJ, Pecorelli S. Gynecological sarcomas. Semin Surg Oncol 1994; 10: 369-73.
Kosary CL. FIGO stage, histology, histologic grade, age and race as prognostic factors in determining survival for cancers of the female gynecological system: an analysis of 1973-87 SEER cases of cancers of the endometrium, cervix, ovary, vulva, and vagina. Semin Surg Oncol 1994; 10: 31-46.